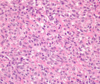

musculoskeletal tumors Flashcards
benign x ray findings
- well defined, clear outline 2. surrounding rim of bone 3. not broken through the cortex 4. narrow zone of transition between lesion, normal bone
name 3 bone cancers
- osteoid osteoma - osteosarcoma - osteochondroma all start with O!
name 2 cartilage cancers
- enchondroma - chondrosarcoma
demographic of osteoid osteoma
usually patients under 20 or 25
benign cordial reaction with a radiolucent nidus
osteoid osteoma
location of osteoid osteoma
diaphysis
NSAIDs work in
osteoid osteoma
symptoms of osteoid osteoma
intense pain at rest/night in the long bone… no systemic symptoms
fever with osteoid osteoma?
no
osteosarcoma
soft tissue mass
associated with Rb
osteosarcoma
demographic of osteosarcoma
typically age 5-25, common in 10-20
may be secondary to Pagets disease
osteosarcoma
complications of Paget disease in the elderly
osteosarcoma and high output heart failure
imaging shows a mixed Lucent and dense “sunburst” lesion (also has ill defined borders)
osteosarcoma
pleomorphic cells producing osteoid
osteosarcoma
malignant osteoblast proliferation
osteosarcoma
Codmans angle
osteosarcoma
location of osteosarcoma
metaphyseal
usually grows away from the metaphysis
osteochondroma
demographic of osteochondroma
childhood
can be sessile or pedunculated
osteochondroma
multiple hereditary exostoses
multiple osteochondromas
inheritance pattern of multiple osteochondromas
autosomal dominant